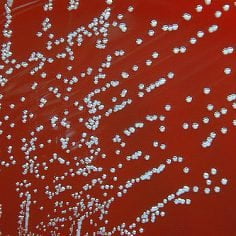
bruceloza

Choroby zakaźne
Czym są choroby zakaźne? Ich dokładna definicja dostępna jest w Ustawie o zapobieganiu oraz zwalczaniu zakażeń i chorób zakaźnych z 5 grudnia 2008 roku. Według ustawy chorobą zakaźną nazywa się taką, która została wywołana przez biologiczne czynniki chorobotwórcze i stanowi zagrożenie dla zdrowia publicznego. To wskazuje na to, że choroby zakaźne są groźne nie tylko dla osoby zakażonej, ale także dla ogółu społeczeństwo. Doświadczamy tego między innymi w czasie pandemii koronawirusa. W tej kategorii przygotowaliśmy dla Was liczne teksty dotyczące chorób zakaźnych.
Co może powodować występowanie chorób zakaźnych?
Choroby zakaźne powstają na wskutek infekcji. Powstają one przede wszystkim w wyniku osłabienia odporności organizmu, przez co infekcja może swobodnie rozwijać się w ciele człowieka. Wśród czynników chorobotwórczych znajdują się:
- wiroidy i wirusy;
- priony;
- grzyby;
- riketsje i bakterie;
Niektóre choroby zakaźne mogą być przenoszone ze zwierząt na człowieka, co czyni je niezwykle groźnymi.
Jak można się zarazić?
Do zarażenia chorobą zakaźną dochodzi najczęściej w wyniku kontaktu z chorym człowiekiem lub innym nosicielem. Medycyna określa następujące drogi rozprzestrzeniania się zakaźnych chorób:
- kontakt z nosicielem lub osobą chorą;
- kontakt z zakażonymi powierzchniami i przedmiotami;
- spożywanie zakażonego pokarmu i napojów;
- kontakt z zanieczyszczona glebą;
- poprzez układ oddechowy;
- poprzez kontakt z nasieniem lub krwią osoby zarażonej;
- poprzez wektory, np. ugryzienia komarów, kleszczy i gryzoni.
Przykładowe objawy chorób zakaźnych
Objawy chorób zakaźnych mogą być bardzo różne w zależności od tego, z jaką chorobą mamy do czynienia. Wpływ na obawy ma również czynnik infekcyjny. U osób chorych wstępują między innymi ból głowy, czy też kaszel i gorączka, które często są źle diagnozowane jako przeziębienie lub grypa. Zakażona osoba może odczuwać również przewlekłe zmęczenie, a w niektórych przypadkach infekcje przebiegają bez objawów.
Aby w porę zdiagnozować chorobę zakaźną, warto obserwować to jak funkcjonuje nasz układ odpornościowy, czy też układ pokarmowy. W przypadku niepokojących objawów niezbędne jest skontaktowanie się z lekarzem specjalistą.
Przykłady chorób zakaźnych
Medycyna określa podział chorób zakaźnych ze względu na ich pochodzenie. Dzięki temu dzielimy je przede wszystkim na:
- choroby wirusowe, np.: grypa, COVID-19, AIDS, ospa wietrzna, świnka, odra;
- choroby bakteryjne, np.: borelioza, dur brzuszny, kiła, dżuma, cholera, błonica gruźlica;
- choroby prionowe, np.: gąbczaste zwyrodnienie mózgu, choroba Creutzfeldta-Jakoba;
- riketsjozy, np.: gorączka plamista;
- choroby grzybicze, np.: kandydoza, aspergiloza, kryptokokoza.
To najważniejsze informacje o chorobach zakaźnych. Zdecydowanie więcej danych i informacji na temat ich przebiegu i leczenia znajdziecie w zamieszczonych w tym miejscu artykułach.
Popularne kategorie w dziale Choroby i zdrowie
- Alergia
- Badania
- Ból
- Choroby Genetyczne
- Choroby Kobiece
- Choroby Męskie
- Choroby nowotworowe
- Choroby pasożytnicze
- Cukrzyca
- Dermatologia
- Laryngologia
- Leki
- Oczy
- Otyłość
- Przeziębienie oraz grypa
- Psychiatria
- Seks
- Skóra
- Układ hormonalny
- Układ kostno-stawowy
- Układ krwionośny
- Układ moczowy
- Układ nerwowy
- Układ oddechowy
- Układ odpornościowy
- Układ pokarmowy
- Urazy
- Witaminy
- Zęby